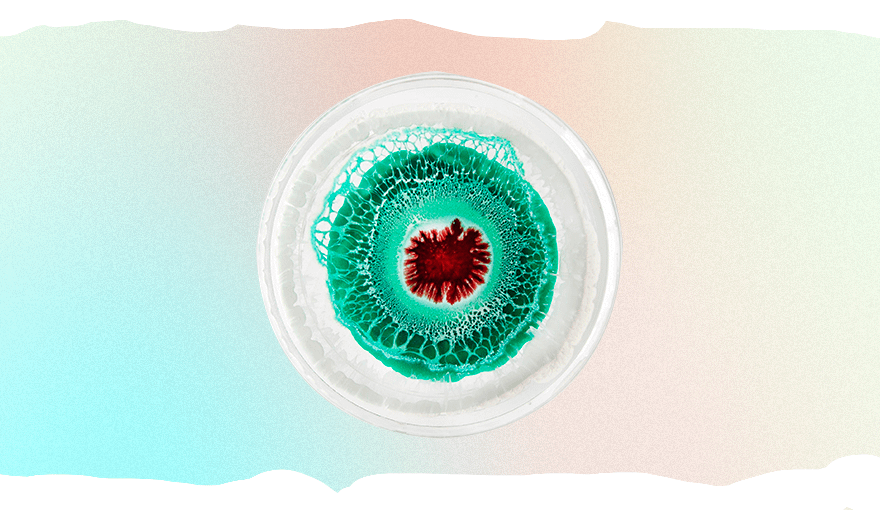

1. Депрессия и СДВГ
Исследование, проведенное в 2006 году, показало, что дочери часто наследуют депрессию от своих матерей. А вот отцы в меньшей степени передают детям обоих полов генетическую предрасположенность к этому заболеванию.
Но депрессия – не единственное психическое расстройство, обусловленное генами. В 2010 году ученые из США обнаружили, что СДВГ также может обуславливаться наследственностью. Он чаще проявляется у детей, в организме матерей которых был низкий уровень серотонина — гормона, необходимого для регуляции и стабилизации настроения человека. Примечательно, что дефицит этого гормона у отцов на психическое здоровье потомства влияет в меньшей степени.
2. Особенности процесса старения
На то, как люди меняются с возрастом, влияет множество факторов: от особенностей их образа жизни до условий окружающей среды. Генетика тоже играет роль в предрасположенности к тем или иным процессам старения.
Исследование, проведенное в Швеции в 2013 году, показало, что особое значение в характере возрастных изменений играют митохондрии. Это части клетки, которые отвечают за ее дыхание и процессы производства энергии. Митохондриальную ДНК дети наследуют только от матери. Нильс-Йоран Ларссон, доктор философии и один из ведущих авторов исследования, объясняет:
3. Стиль сна
Характер сна, поведение в нем и даже расстройства сна с большей вероятностью передаются от мамы, а не от папы — к такому выводу пришли ученые из Швейцарии. Их исследование показало четкую корреляцию между материнской бессонницей и несколькими особенностями сна ребенка. Среди них ученые отметили скорость засыпания, продолжительность каждой фазы сна и его общая длительность, время пробуждения.
В данный момент ученые продолжают ряд исследований, так как не пришли к единому выводу, почему дети наследуют проблемы со сном и особенности циркадного ритма от матери. Исследователи предполагают, что на это могут повлиять аутосомная и митохондриальная ДНК.
4. Умение скручивать язык трубочкой
Забавное умение скручивать язык трубочкой генетически обуславливается наличием в организме доминантного аллеля генов, отвечающих за эту способность. Барри Старр, генетик из США, отмечает:
5. Митохондриальные заболевания
Как мы успели упомянуть ранее, митохондриальную ДНК дети наследуют только от своих матерей. Мутации этих клеток могут влиять не только на процессы старения, но и на склонность к определенной группе заболеваний.
К митохондриальным болезням относятся судорожные расстройства, гипотония, слабость глазных мышц, которая называется офтальмоплегией, кардиомиопатия, то есть поражение сердечной мышцы. Эти заболевания могут проявиться как в детском, так и во взрослом возрасте.
6. Интеллект
Хотя единого «гена интеллекта» не существует, одним из факторов, влияющих на развитие интеллектуальных способностей, является ДНК матери. По словам американского доктора Эми Анзилотти, от нее дети наследуют интеллектуальные способности в большей степени, чем от отца, и этому есть несколько причин.
Во-первых, органы, которым требуется больше всего энергии, имеют большую плотность митохондрий. К ним относится и головной мозг. Соответственно, в нем больше митохондриальной ДНК, которая является наследием матери.
Во-вторых, интеллект в большей степени передается через Х-хромосому. Она оказывает влияние на развитие коры головного мозга, области, которая отвечает за когнитивные способности и социальные функции. Поскольку у мамы две Х-хромосомы, а у папы только одна, скорее всего, больше интеллектуальных генов передаются ребенку от его матери.
Доктор Анзилотти комментирует:
 Читать по теме:5 интересных фактов о генетической памяти
Читать по теме:5 интересных фактов о генетической памяти